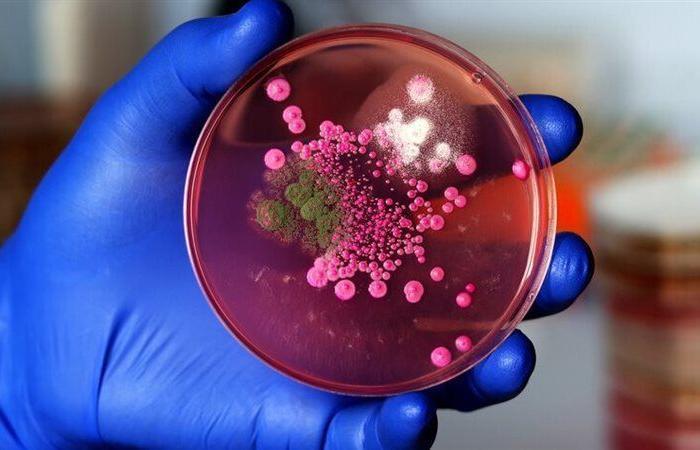

لسبب غير متوقع.. رجل يفقد 22 كغ من وزنه في وقت قياسي!
أفاد فريق من الأطباء بأن رجلا فقد نحو 22.6 كغ من وزنه دون محاولته ذلك، في وقت قياسي نسبيا، ولسبب غير متوقع. فما هو؟
كشف تقرير الحالة أن فطرا قاتلا “يتكاثر في براز الخفافيش” أدى إلى معاناة رجل مقيم في فلوريدا (عمره 61 عاما)، من التعرق الليلي والتعب الشديد والحمى وفقدان الوزن الكبير خلال 10 أشهر تقريبا، ما استدعى دخوله المستشفى.
وأظهرت الاختبارات أنه مصاب بمستويات عالية من فطر Histoplasma capsulatum، الذي أضر بقلبه، ما أدى إلى التهاب في جميع أنحاء هذا الجسم، وتسبب في تضخم طحاله ونمو كتلتين على الغدد الكظرية.
وكتب الأطباء في التقرير أن الرجل كان محظوظا لأنه على قيد الحياة، خاصة أنه يعاني من مرض السكري وارتفاع ضغط الدم وعدم انتظام ضربات القلب.
وتعد العدوى الفطرية الشديدة قاتلة بنسبة 100% إذا تُركت دون علاج لدى الأشخاص الذين يعانون من ضعف المناعة.
وكان على الرجل أن يخضع لعمليات جراحية في القلب لإصلاح المناطق التالفة منه، ووصف له الأطباء دواء وريديا لمدة أسبوعين، ولكنه عانى من مضاعفات بعد العمليات، وتم إدخاله إلى وحدة العناية المركزة لمدة 6 أيام. كما عانى من فقر الدم بسبب فقدان كمية كبيرة من الدم، وتدهور وظائف الكلى بسبب تلف الخلايا في الأعضاء.
وبمجرد تعافيه، تم إرسال الرجل إلى المنزل لتلقي علاج مضاد للفطريات “طويل الأمد”.
وأوضح الأطباء أن فطر H. capsulatum يتواجد في براز الطيور والخفافيش ويسبب مرضا يشبه الإنفلونزا عندما يستنشق الناس جراثيمه. لكن المريض أوضح أنه لم يكن على اتصال بهذه الحيوانات، ولم يسافر خارج فلوريدا مؤخرا.
ومع ذلك، يمكن لـ H. capsulatum تلويث التربة والعيش في الأرض لسنوات.
وجاء في تقرير الحالة: “يتطلب الفطر بيئة تدعم نموه، والتي تشمل عادة مناطق بها كميات كبيرة من فضلات الطيور أو الخفافيش”.
يذكر أن تشخيص الفطريات ليس أمرا شائعا في فلوريدا، فهي أكثر انتشارا في وادي نهر أوهايو ونهر المسيسيبي. وتشير مراكز السيطرة على الأمراض والوقاية منها إلى أن هذه المناطق تعد موقعا “مناسبا” لنمو H. capsulatum بسبب حموضة التربة.
لذا، بعد الإبلاغ عن الحالة هذه، أُخذت عينات من تربة مزرعة الرجل “لكشف سر انتشار الفطريات في المنطقة”.


